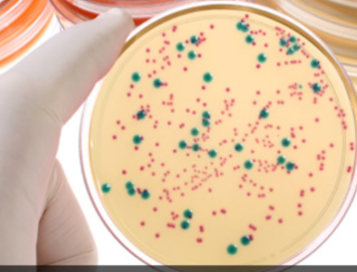

Sign up for FlowVella
Sign up with FacebookAlready have an account? Sign in now
By registering you are agreeing to our
Terms of Service
Loading Flow




What type of work does a biochemical engineer do?

Biochemical Engineers perform research along with sharing discoveries with others. They also do a lot of experiments and lab work. They study cells and other organisms often as well.